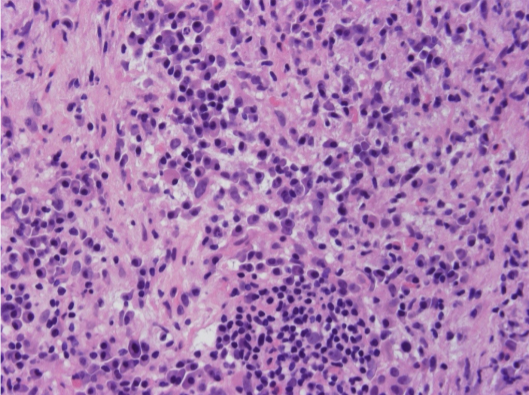
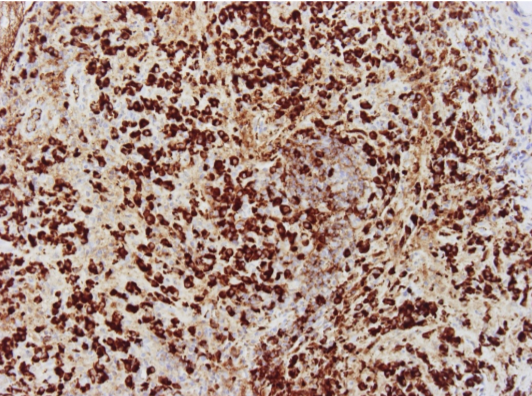

What does HIV cause?
Opportunistic Infections
Tumours
Central nervous system diseases
Which opportunistic infections are associated with HIV?
Pneumocystis jiroveci: Pneumonia
CMV: Especially retina and GIT
Candida
Tuberculosis and atypical mycobacteria
Cryptococcus: Meningitis
Toxoplasma gondii: Encephalitis and mass lesions
JC papovavirus: Progressive multifocal leukoencepalopathy
Herpes simplex
Cryptosporidium, Isospora belli, microsporidia: GIT
Which tumours are associated with HIV?
Kaposi’s sarcoma: HHV-8
Lymphoma:
Others:
What is this and what are the defining features of these?

Kaposi’s Sarcoma
A. The dermis is expanded by a solid tumour.
B. Fascicles of relatively monomorphic spindled cells, with slit-like vascular channels containing erythrocytes.
C. The nuclei of the tumour cells demonstrate immunoreactivity for HHV-8.
Which central nervous system diseases can be caused by HIV?
Progressive encephalopathy: AIDS dementia complex.
Plus opportunistic infections and tumours.
What are these?

A. Tumour mass.
B. Perivascular lymphomatous infiltrate.
What is the pathology of mycobacteria?
Caseating granulomas
Demonstration of acid fast bacilli
What is this?

Cavitating TB
What is this?

Granuloma with caseous necrosis
Which organs can be affected by mycobacterial infection?
Lung
Lymph node
Bone: e.g. Vertebra
Heart: e.g. Pericarditis
GIT: e.g. Peritonitis
CNS: e.g. Meningitis
What is the pathology of sarcoidosis?
Non-caseating granulomas
A diagnosis of exclusion
Which organs can be affected in sarcoidosis?
Lung: Scattered granulomas, heal with fibrosis
Lymph nodes: Usually hilar and mediastinal
Spleen
Liver
Heart
Joints
Bone marrow
Skin: Nodules, plaques or macules
Eyes: Iritis, choroid retinitis, lacrimal glands
CNS
Salivary glands
What are signs and symptoms of sarcoidosis?
Brain complications
Enlarged lymph nodes in neck and chest
Granulomas and scar tissue in lungs
Enlarged liver
Erythema nodosum
Eye problems
Skin lesions
Heart complications
Enlarged spleen
Join problems (arthritis)
What is the pathology of IgG4 related disease?
Inflammation dominated by IgG4 antibody producing plasma cells.
Fibrosis, obliteration of veins.
What is this?
Plasma cell rich, inflammatory infiltrate
What is this?
Immunohistochemistry for IgG4
Which organs can be affected in IgG4 related disease?
Salivary and lacrimal glands: Mikulicz syndrome.
Thyroid: Riedel thyroiditis.
Peritoneum: Retroperitoneal fibrosis.
Liver: Biliary obstruction.
Pancreas: Autoimmune pancreatitis.
Mass lesions: Inflammatory pseudotumour
Which organs can alcohol affect?
Liver:
GI Tract:
Nervous system:
Cardiovascular system:
Pancreas:
Fetal alcohol syndrome
Cancer: Oral cavity, pharynx. oesophagus, liver and breast
Which organs can be affected by cystic fibrosis?
Pancreas: Duct obstruction, exocrine atrophy.
Salivary glands: Duct obstruction, atrophy.
Intestine: Meconium ileus.
Liver: Biliary obstruction, cirrhosis.
Lung: Bronchial obstruction, superimposed infection with abscess formation (Staphylococcus aureus, Haemophilus influenzae and Pseudomonas aeruginosa.
Male genital tract: Infertility, absence of the vas
What is the pathology of amyloidosis?
Deposition of an abnormal proteinaceous substance in non branching fibrils, 7.5-10nm diameter.
Always contains P component.
Beta-pleated sheet structure.
A variety of proteins can take on this conformation.
Resistant to enzymic degradation.
What is the classificiation of amyloidosis?
What is another classification of types of amyloidosis?
Transthyretin: Mutation
Beta2-macroglobulin: Peritoneal dialysis
Abeta2 protein: Alzheimer’s
Insulin, calcitonin: Endocrine tumours
Which staining is used for amyloidosis?
Stains with Congo Red dye.
This shows apple green birefringence under polarised light.
What are the clinical features of amyloidosis?
Proteinuria, renal failure.
Restrictive cardiomyopathy, arrhythmias.
Autonomic neuropathy.
Carpal tunnel syndrome.
Macroglossis
Bleeding on injury
Also deposited in blood vessels, endocrine organs, liver, spleen.